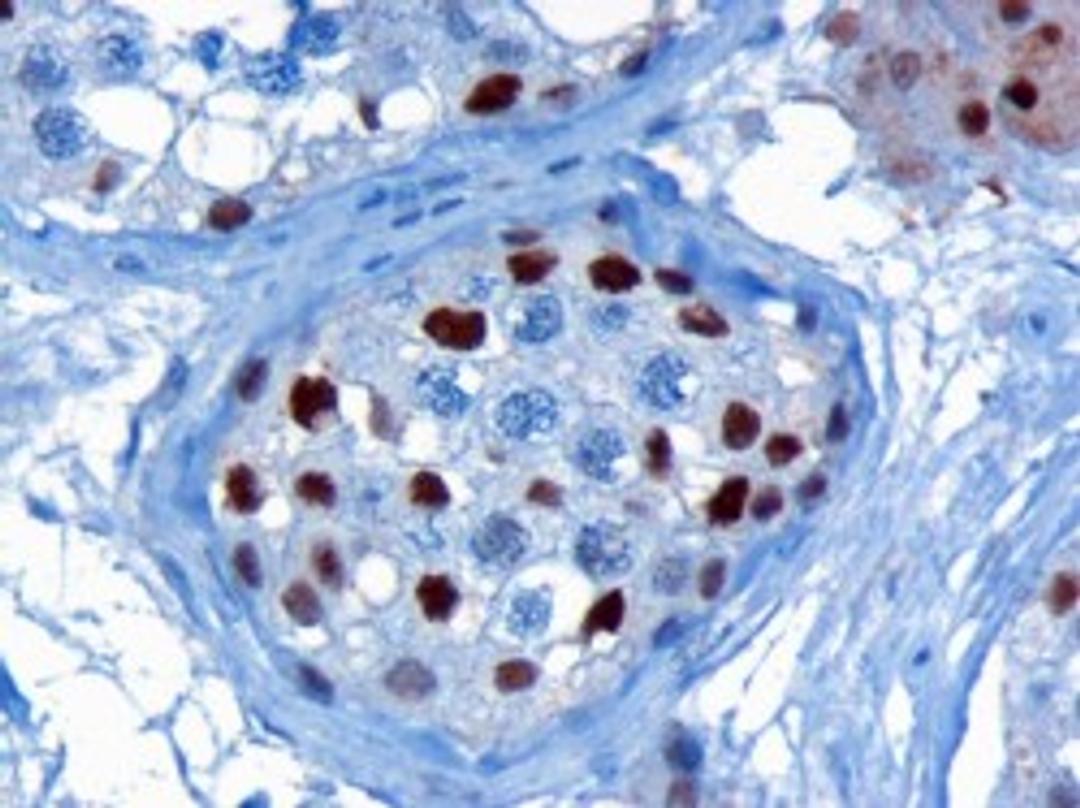
45-814 (3ug/ml) staining of paraffin embedded Human Testis. Microwaved antigen retrieval with citrate buffer pH 6, HRP-staining.

Product & ReviewsAntibodies
KPNA4 Antibody
Product Details
- Cat. No.
- 45-814
- Type
- Primary Antibody
- Clonality
- Polyclonal
- Host
- Goat

The supplier does not provide quotations for this antibody through SelectScience. You can search for similar antibodies in our Antibody Directory.
Biological Information
- Clonality: Polyclonal
- Host: Goat
- Antigen: KPNA4
- Source: KPNA4 antibody was purified from goat serum by ammonium sulphate precipitation followed by antigen affinity chromatography using the immunizing peptide.
- Gene: 3840
Handling
- Quantity: 0.1 mg
- Storage: Aliquot and store at -20°C. Minimize freezing and thawing.
- Buffer: KPNA4 antibody is supplied in Tris saline, 0.02% sodium azide, pH 7.3 with 0.5% bovine serum albumin.